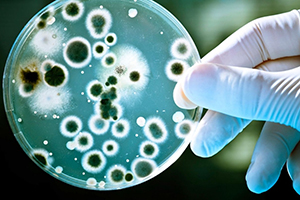

БРУЦЕЛЛЕЗ
Бруцеллез зоонозная хронически протекающая инфекционная болезнь животных, характеризующая абортами, рождением мертвого или нежизнеспособного приплода, артритами и бурситами. Клинические признаки болезни проявляются при достижении животными половой зрелости. Возбудителем бруцеллеза являются бактерии рода бруцелла. Возбудитель устойчив к воздействию окружающей среды, сохраняется в молоке до 10 календарных дней, в сливочном масле до 35 календарных дней, во внутренних органах, костях, мышцах и лимфатических узлах инфицированных туш до 60 дней. Инкубационный период при бруцеллезе составляет от 2 до 4 недель, Источниками возбудителя являются больные животные, их секреты и экскреты. Возбудитель передается алиментарным путем при контакте с больными животными, с абортированными плодами, плодными оболочками и околоплодной жидкостью, через поврежденную кожу, слизистые оболочки дыхательных путей и желудочно-кишечного тракта, через слизистые оболочки половых органов, при контакте с продукцией животного происхождения, полученной от больных животных. Факторами передачи возбудителя являются продукция животного происхождения, корма, вода, а также персонал, контактировавший с больными животными. Согласно «Ветеринарных правил осуществления профилактических, диагностических ограничительных и иных мероприятий, установления и отмены карантина и иных ограничений, на предотвращение распространения и ликвидацию очагов бруцеллеза» Утвержденных приказом Минсельхоза России от 09.09.2020 года №533 вступивших в силу с 01.03.2021 года.
В целях предотвращения возникновения и распространения бруцеллеза физические и юридические лица, являющиеся собственниками (владельцами) животных обязаны:
Предоставлять по требованиям специалистов Государственной ветеринарной службы животных для осмотра;
Принимать меры по изоляции подозреваемых в заболевании животных, всех животных, находящихся в контакте с подозреваемыми в заболевании бруцеллезом;
Соблюдать условия, запреты, ограничения в связи со статусом региона, на территории которого расположено хозяйство в настоящее время Большеглушицкий район неблагополучный по бруцеллезу крупного рогатого скота;
Не допускать смешивания из разных стад, отар, групп при их выпасе и водопое.
Все поголовье крупного и мелкого рогатого скота должно быть идентифицировано.
Для исследования на бруцеллез владельцы должны предоставлять животных с 2-х месячного возраста.
В Большеглушицком районе в настоящее время два неблагополучных пункта по бруцеллезу крупного рогатого скота, Южное поселение очаг ООО «Эльмир» поселок Малороссийский и Фрунзенское поселение один очаг в личном подсобном хозяйстве(далее-ЛПХ) в поселке Малый Каралык и шесть очагов в ЛПХ в селе Морша.
В период с мая 2022 года по настоящее время во Фрунзенском поселении регулярно проводятся ветеринарные мероприятия по выявлению больных животных.
Согласно приказа № 533 в эпизоотическом очаге запрещается:
Лечение больных животных, посещение территорий очагов посторонними лицами, кроме обслуживающего персонала и специалистов госветслужбы, ввоз, вывоз животных, за исключением вывоза животных на убой на специализированные для этих целей убойные пункты, вывоз и использование молока, за исключением молока, прошедшего термическую обработку. Выпас, перемещение и перегруппировку животных, заготовка и вывоз кормов, с которыми могли иметь контакт больные животные, вывоз инвентаря и иных материально-технических средств, использование водоемов, не связанных с другими поверхностными водными объектами, для водопоя здоровых в течение 90 календарных дней после последнего поения из них больных животных. Охота на животных, отнесенных к охотничьим ресурсам, за исключением охоты в целях регулирования численности охотничьих ресурсов.
Напоминаю, что согласно статья 18. Закона о ветеринарии -Ответственность за здоровье, содержание и использование животных несут их владельцы, а за выпуск безопасных в ветеринарно-санитарном отношении продуктов животноводства — производители этих продуктов.
Начальник –ветеринарный врач
Большеглушицкой СББЖ
А.В. Игуменов